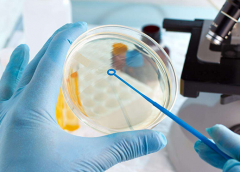
取卵后实验室培养过程，建议你多看看！

试管科普

-
 促排期间,奶茶诱惑下的排卵秘密:量多真的会影响吗?
促排期间,奶茶诱惑下的排卵秘密:量多真的会影响吗?奶茶中的咖啡因和茶多酚等成分可能干扰激素平衡,从而影响卵泡的发育和排卵的正常进行。因此,在进行试管前的养卵期间,最好避免过量饮用奶茶。而且,不仅是奶茶,其他含有咖啡
作者:木易 191 发布时间:2026-04-14 -
 试管前,情绪管理为何成为成功的关键?
试管前,情绪管理为何成为成功的关键?情绪稳定有助于调节生理功能,提高成功率。情绪不稳定可能影响荷尔蒙分泌,影响受精卵着床。因此,学会调整情绪对于试管过程至关重要。情绪调整可以通过心理咨询、放松技巧和支
作者:木易 188 发布时间:2026-04-14 -
 谣言止于智者,马来西亚揭示试管真相:90%非亲生是谬论!
谣言止于智者,马来西亚揭示试管真相:90%非亲生是谬论!这一荒谬谣言,马来西亚方面明确澄清,完全缺乏事实依据。试管技术作为一项先进的辅助生殖手段,其核心目的正是为了帮助那些面临自然怀孕困难的夫妇圆满他们的生育梦想。实际上,
作者:wednesday 162 发布时间:2026-04-14 -
 试管单腔取卵适合哪些人做?安全性怎么样?
试管单腔取卵适合哪些人做?安全性怎么样?适用试管单腔取卵的人群包括以下情况:女性输卵管无法正常拾卵,输卵管梗阻的患者,如曾经做过宫外孕、行过结扎手术、卵巢囊肿手术等;男性少精、弱精,或无精症;夫妻双方结婚超过5年
作者:木易 119 发布时间:2026-04-14 -
 人工周期转针是什么意思,具体步骤有哪些?
人工周期转针是什么意思,具体步骤有哪些?试管人工周期转针的具体步骤包括:术前检查、促排卵、内膜准备和移植。在术前检查阶段,医生会进行全面检查,制定有针对性的促排卵方案。接着是促排卵阶段,通过药物促进卵巢排卵,
作者:木易 115 发布时间:2026-04-14 -
 一分钟读懂什么是CET技术?有什么优势?
一分钟读懂什么是CET技术?有什么优势?在不孕夫妇中,CET为他们带来了新的希望和机会。通过CET,医生将培育良好的胚胎移植到女性子宫内,促使受精卵着床并发育成胎儿。这一过程为不孕夫妇打开了通往生育的大门,为他们带来
作者:木易 188 发布时间:2026-04-14 -
取卵后实验室培养过程,建议你多看看!
取卵后实验室培养过程,建议你多看看!首先,医生会将取卵后的卵子送到实验室,然后专业医生会迅速处理卵子,去除卵周围的颗粒细胞,评估卵子的成熟度,并将观察到的卵子转移到培养瓶中进行培养。接下来的步骤包括处理精
作者:木易 188 发布时间:2026-04-14 -
 什么是试管二步移植法?费用贵吗?
什么是试管二步移植法?费用贵吗?这种方法在一个试管周期内,先移植初期胚胎,然后在几天后再移植一个囊胚,以增加移植成功的几率。二步移植法也容易导致双胞胎的出现。除了费用,试管还涉及手术费用和术前
作者:木易 186 发布时间:2026-04-14 -
 什么是AOA卵子加二代试管?有助于提高成功率
什么是AOA卵子加二代试管?有助于提高成功率在试管过程中,卵子的质量和数量对受孕率起着重要作用。而AOA卵子指的是采用一种特殊的养卵方法——自体卵子激活技术,它通过使用特定的生物活性物质来改善卵子的质量和活力。这
作者:木易 138 发布时间:2026-04-14 -
 试管双胞胎流程,想生的建议先了解清楚
试管双胞胎流程,想生的建议先了解清楚试管双胞胎的形成可以有几种类型。一种是单卵双胎,即一个胚胎在早期发育时分裂成具有相同基因的两个胎儿。另一种是双卵双胎,即将两个胚胎移植到子宫,各自独立发育成一个胎儿
作者:木易 71 发布时间:2026-04-14 -
 辅助生殖期间不要喝酒,尤其是取卵后要特别注意!
辅助生殖期间不要喝酒,尤其是取卵后要特别注意!酒精摄入可能对身体产生负面影响,如影响子宫内膜的准备情况,降低胚胎着床的成功率。因此,在进行辅助生殖治疗期间,特别是在取卵后的关键时期,建议避免过量饮酒,以确保最佳的移
作者:木易 123 发布时间:2026-04-14 -
 女性能排卵就能做试管?还需要满足以下条件!
女性能排卵就能做试管?还需要满足以下条件!有排卵并不意味着就能进行辅助生殖治疗。在考虑进行辅助生殖治疗前,有一些要求必须得到满足。首先,女性的卵巢功能需要正常,排卵周期规律,子宫内膜厚度和形态符合移植要求。其次
作者:木易 85 发布时间:2026-04-14
